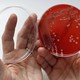

How Antibiotic Resistance Could Make Common Surgeries More Dangerous
If prophylactic antibiotics get 30 percent less effective, there will be 120,000 more infections in the U.S. every year from procedures like C-sections and appendectomies.
An appendectomy is the white bread of surgeries. It’s common, it’s low-risk, and it only takes an hour or two to perform. Even the children’s-book character Madeline had her appendix out, and it was so not a big deal that at the end of the book, the other girls who lived in the “old house in Paris that was covered with vines” complained that they wanted to get their appendixes out too, so they could get presents and have a cool scar.
But still, any surgery involves cutting someone open and sewing them back up again. And no matter how quotidian the procedure, when you open somebody’s body up, there’s a risk of infection.
To help reduce this risk, many surgical patients are given prophylactic antibiotics. But with the rise of antibiotic-resistant bacteria, that strategy may become less and less effective. A new study published in The Lancet Infectious Diseases by researchers at the Center for Disease Dynamics, Economics, and Policy examines just how much less.
The study looks at two types of meta-analyses (making it a meta-meta-analysis): of infection-related deaths, and of the effectiveness of antibiotic prophylaxis in preventing infections for chemotherapy and the 10 most common surgical procedures in the United States.
Because of the number of factors that go into surgical-site infections, it’s really hard to know how many of them are caused by antibiotic-resistant bacteria. So the researchers did a projection of how many more infections would happen each year if antibiotic prophylaxis for these procedures became 10 percent less effective, 30 percent less, 70 percent less, and 100 percent less. (These numbers aren’t crazy—the prevalence of certain resistant bacteria has been skyrocketing. For example, from 1987 to 2004, instances of methicillin-resistant Staphylococcus aureus, better known as MRSA, in hospitals increased by 2,400 percent.)
If antibiotics became 30 percent less effective when used before surgery, that would result in 120,000 more infections a year, and 6,300 deaths from those infections. And that’s just from the top 10 surgeries and chemotherapy, and only in the U.S.
Additional Infections Per Year Under a 30 Percent Decreased Efficacy of Antibiotic Prophylaxis

For an even less rosy view, a 70 percent reduction in efficacy would mean 280,000 more infections and 15,000 more deaths. From surgeries like C-sections and appendectomies.
Perhaps in the future, Madeline will be a cautionary tale to haunt children’s dreams instead of lulling them to sleep.